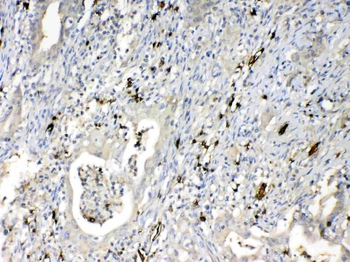
HBD Rabbit Polyclonal Antibody
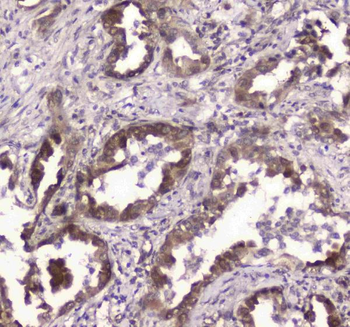
GLO1 Rabbit Polyclonal Antibody

You have no items in your shopping cart.
All Products
- Featured
 betaIII-Tubulin Antibody [orb44544]Featured
betaIII-Tubulin Antibody [orb44544]Featured
FC, ICC, IHC-P, WB
Canine, Human, Mouse, Porcine, Rat
Monoclonal
Unconjugated
0.1 mg - HBD Rabbit Polyclonal Antibody [orb402431]
ELISA, IHC, WB
Human, Mouse, Rat
Rabbit
Polyclonal
Unconjugated
100 μg - Cyclophilin B/PPIB Rabbit Polyclonal Antibody [orb402523]
ELISA, FC, ICC, IF, IHC, WB
Human, Mouse, Rat
Rabbit
Polyclonal
Unconjugated
100 μg IF, IHC, WB
Human, Mouse, Rat
Rabbit
Polyclonal
Unconjugated
100 μg- MED15 Rabbit Polyclonal Antibody [orb402534]
ELISA, FC, ICC, IF, IHC, WB
Human, Mouse, Rat
Rabbit
Polyclonal
Unconjugated
100 μg - GSTM3 Rabbit Polyclonal Antibody [orb402287]
ELISA, IHC, WB
Human, Mouse
Rabbit
Polyclonal
Unconjugated
100 μg - GLO1 Rabbit Polyclonal Antibody [orb402257]
ELISA, ICC, IHC, IP, WB
Human, Mouse, Rat
Rabbit
Polyclonal
Unconjugated
100 μg - CD44 Rabbit Polyclonal Antibody [orb402179]
ELISA, FC, ICC, IF, IHC, IHC-Fr, WB
Human, Mouse, Rat
Rabbit
Polyclonal
Unconjugated
100 μg